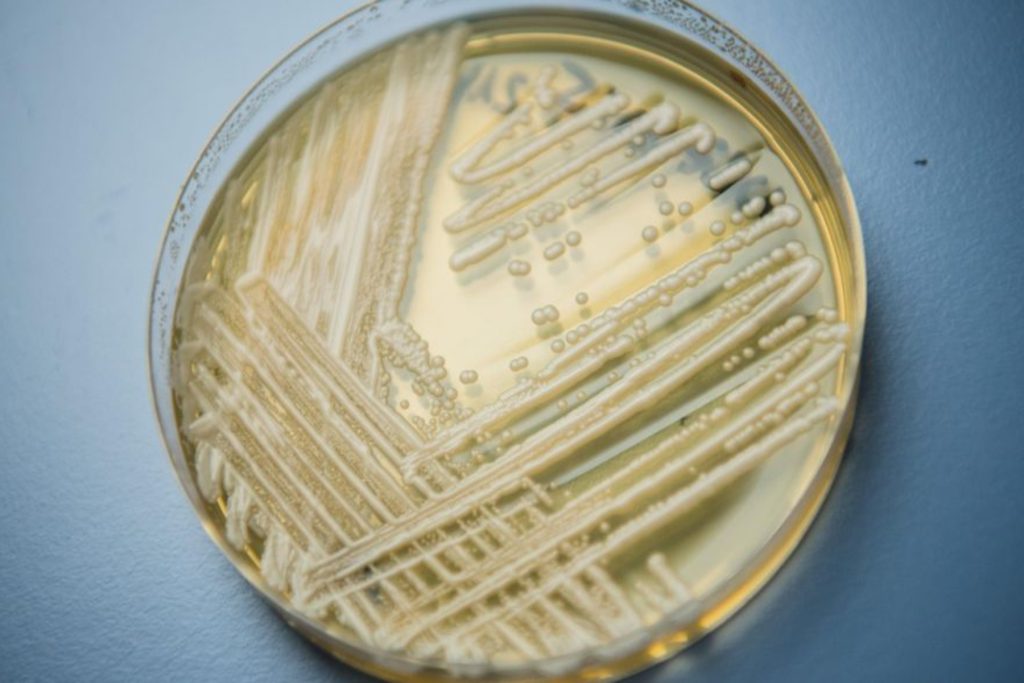

Ο Α.Σαμαράς θα «τελειώσει» δύο κόμματα όταν κατέβει...
ΣΥΜΒΑΙΝΕΙ ΤΩΡΑ
-
Επαναστατικό επίθεμα κατά του καρκίνου: Μειώνει τους όγκους έως 97% μέσα σε 10 μέρες
-
Βίντεο: Οι Ρώσοι βομβαρδίζουν στην Κονσταντινόφκα τους τελευταίους Ουκρανούς με λευκό φώσφορο
-
Επιστήμονες κατηγορούνται ότι εισήγαγαν στις ΗΠΑ λαθραία δείγματα του ιού ευλογιάς των πιθήκων
-
Καλαμάτα: Σήμερα απολογείται ο 41χρονος που σκότωσε με 45 μαχαιριές την 39χρονη σύζυγό του – Τι θα υποστηρίξει
-
Μετά από 82 χρόνια βρέθηκε το ναυάγιο του ιστορικού αμερικανικού υποβρυχίου USS Herring ανοιχτά της νήσου Matsua
-
Βίντεο: Η στιγμή που γυναίκα επιτίθεται σε 23χρονη Εβραία μέσα στο μετρό της Ν.Υόρκης & της ξεριζώνει τούφα μαλλιών
-
Απίστευτο περιστατικό στην Ουκρανία: Ζαρκάδι έπεσε πάνω σε ηλικιωμένη και την έριξε στο δρόμο (βίντεο)
-
Ν.Τραμπ κατά δημοσιογράφου του CNN: «Είσαι διεφθαρμένη και έχεις τόσο μίσος στα μάτια σου»!
-
Πάτρα: Νέος θάνατος κρατουμένου στις φυλακές Αγίου Στεφάνου – Στους επτά ο συνολικός αριθμός μέσα σε λίγες βδομάδες
-
Ισραήλ και Λίβανος συμφώνησαν σε πλήρη κατάπαυση του πυρός αλλά όλα εξαρτώνται από την Χεζμπολάχ